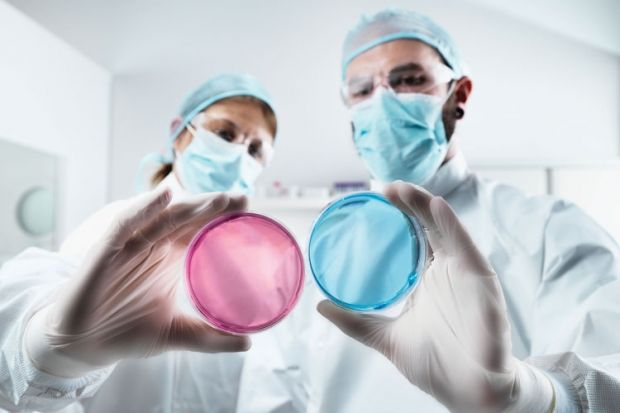

The Athena SWAN Charter for Women in Science, the scheme that encourages gender equality in science disciplines within the academy, is expanding to cover the arts, humanities and social sciences.
A new award, called the gender equality charter mark, covering the subject areas will follow the model of the Athena SWAN charter, with institutions and individual departments able to apply for bronze, silver and gold status.
Although in the immediate future the two schemes will run in parallel, the Equality Challenge Unit, which manages both, hopes eventually to bring the two together, said Gary Loke, head of policy at the unit.
The charter is likely to find strong support from institutions already engaging with the Athena SWAN award, he said.
Applications soared after it was linked to research funding by the Department of Health in 2011, with the number of applications trebling between 2012 and 2013. “As Athena SWAN has gained traction over the last few years, what we recognised was that actually a lot of the core issues in the [science] disciplines were the same across the board.”
A trial of the arts, humanities and social sciences charter mark, launched on 25 July, follows a successful pilot led by the University of Reading.
It will run in up to 30 institutions until spring 2014 and is aimed in particular at small specialist institutions and conservatoires that would not previously have had a need to engage with the science-based Athena SWAN awards.
Awards will be given to departments that can show progress in hiring and retaining women, providing career support, helping to achieve a better work-life balance, and demonstrating gender equality in making senior appointments.
A difference with the new charter is that it will also cover professional and support staff, who Mr Loke said had a less formalised career ladder. Additionally, it will recognise a wider range of equality issues, including those faced by transgender staff, and address the under-representation of men involved in, for example, the early stages of an academic career in education or social work.
As previously, departments will be able to apply for recognition in their own right only once the institution achieves a bronze award.
When the science and arts charters are eventually brought together, universities will have to hold this single award for individual departments to be recognised. Mr Loke said that those already holding science awards will be given time and support to gain the combined award.
Register to continue
Why register?
- Registration is free and only takes a moment
- Once registered, you can read 3 articles a month
- Sign up for our newsletter
Subscribe
Or subscribe for unlimited access to:
- Unlimited access to news, views, insights & reviews
- Digital editions
- Digital access to THE’s university and college rankings analysis
Already registered or a current subscriber?